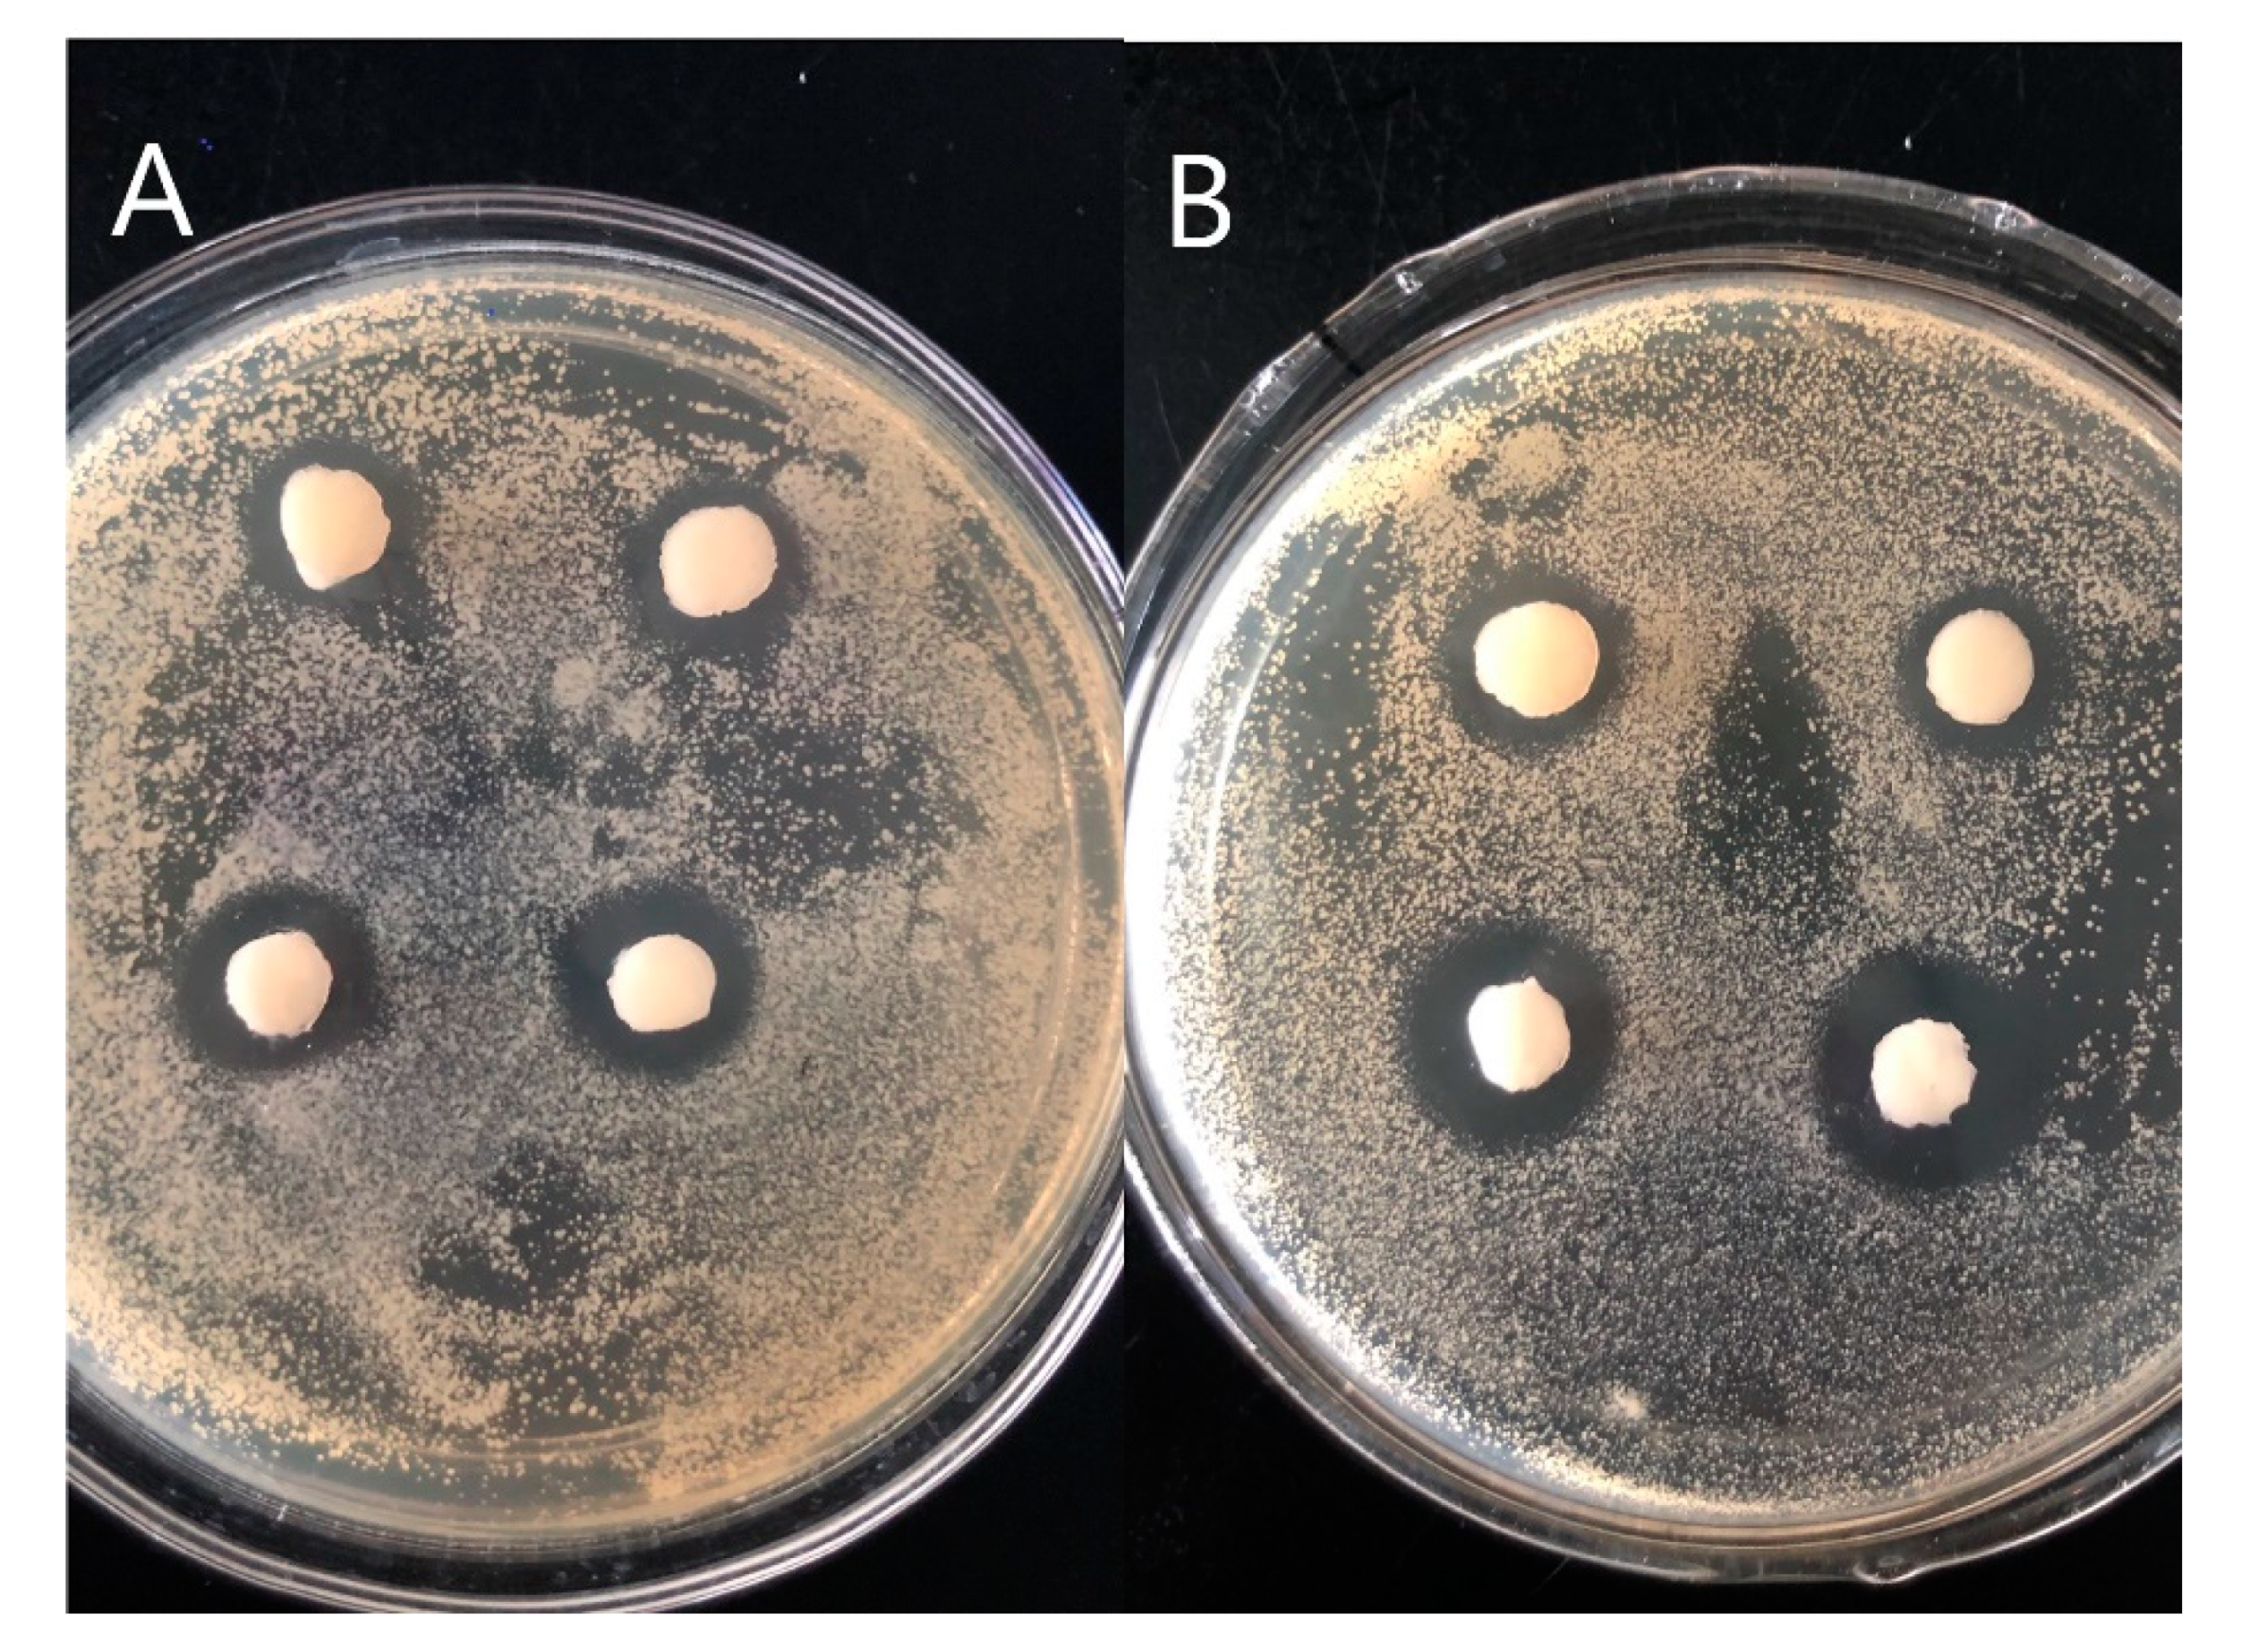
Polymers 12 01729 g007 Polymers 12 01729 g007

Physically Crosslinked Hydrogels Based on Poly (Vinyl Alcohol) and Fish Gelatin for Wound Dressing Application: Fabrication and Characterization
Abstract
1. Introduction
2. Materials and Methods
2.1. Materials
2.2. Preparation of Hydrogel
2.2.1. Preparation of PVA/FG Composite Hydrogel
2.2.2. Preparation of Drug-Loaded PVA/FG Hydrogel
2.3. Characterization of Hydrogels
2.3.1. Measurement of Color Values
2.3.2. Determination of Water Content in Hydrogels
2.3.3. Swelling Properties
2.3.4. Swelling Kinetic Study
2.3.5. Measurement of Water Evaporation Rate
2.4. The Estimation of Drug Release In Vitro
2.5. Antibacterial Activity Test
2.6. Statistical Analysis
3. Results and Discussion
3.1. Sensory Characteristics of Hydrogels
3.2. The Water Content of Hydrogels
3.3. Swelling Behavior Analysis
3.4. Water Evaporation Rate Analysiss
3.5. Swelling Kinetics
3.6. In Vitro Salicylic Acid Release
3.7. Antibacterial Activity
4. Conclusions
Author Contributions
Funding
Acknowledgments
Conflicts of Interest
References
- Liu, H.; Wang, C.Y.; Li, C.; Qin, Y.G.; Wang, Z.H.; Yang, F.; Li, Z.H.; Wang, J.C. A functional chitosan-based hydrogel as a wound dressing and drug delivery system in the treatment of wound healing. RSC Adv. 2018, 8, 7533–7549. [Google Scholar] [CrossRef]
- Kamoun, E.A.; Kenawy, E.R.S.; Chen, X. A review on polymeric hydrogel membranes for wound dressing applications: PVA-based hydrogel dressings. J. Adv. Res. 2017, 8, 217–233. [Google Scholar] [CrossRef] [PubMed]
- Pal, K.; Banthia, A.K.; Majumdar, D.K. Preparation and characterization of polyvinyl alcohol-gelatin hydrogel membranes for biomedical applications. Aaps Pharmscitech 2007, 8. [Google Scholar] [CrossRef] [PubMed]
- Dhivya, S.; Padma, V.V.; Santhini, E. Wound dressings—A review. Biomedicine-Taiwan 2015, 5, 24–28. [Google Scholar] [CrossRef]
- Fan, L.H.; Yang, H.; Yang, J.; Peng, M.; Hu, J. Preparation and characterization of chitosan/gelatin/PVA hydrogel for wound dressings. Carbohydr. Polym. 2016, 146, 427–434. [Google Scholar] [CrossRef]
- Gonzalez, J.S.; Maiolo, A.S.; Hoppe, C.E.; Alvarez, V.A. Composite gels based on Poly (vinyl alcohol) for biomedical uses. Proc. Mat. Sci. 2012, 1, 483–490. [Google Scholar] [CrossRef][Green Version]
- Bullock, A.J.; Pickavance, P.; Haddow, D.B.; Rimmer, S.; MacNeil, S. Development of a calcium-chelating hydrogel for treatment of superficial burns and scalds. Regen. Med. 2010, 5, 55–64. [Google Scholar] [CrossRef]
- Broughton, G.; Janis, J.E.; Attinger, C.E. A brief history of wound care. Plast. Reconstr. Surg. 2006, 117, 6S–11S. [Google Scholar] [CrossRef]
- Dragan, E.S. Design and applications of interpenetrating polymer network hydrogels. A review. Chem. Eng. J. 2014, 243, 572–590. [Google Scholar] [CrossRef]
- Ullah, F.; Othman, M.B.H.; Javed, F.; Ahmad, Z.; Akil, H.M. Classification, processing and application of hydrogels: A review. Mater. Sci. Eng. C Mater. Biol. Appl. 2015, 57, 414–433. [Google Scholar] [CrossRef]
- Hamedi, H.; Moradi, S.; Hudson, S.M.; Tonelli, A.E. Chitosan based hydrogels and their applications for drug delivery in wound dressings: A review. Carbohydr. Polym. 2018, 199, 445–460. [Google Scholar] [CrossRef]
- Kumar, P.T.S.; Lakshmanan, V.K.; Anilkumar, T.V.; Ramya, C.; Reshmi, P.; Unnikrishnan, A.G.; Nair, S.V.; Jayakumar, R. Flexible and Microporous Chitosan Hydrogel/Nano ZnO Composite Bandages for Wound Dressing: In Vitro and In Vivo Evaluation. ACS Appl. Mater. Interfaces 2012, 4, 2618–2629. [Google Scholar] [CrossRef] [PubMed]
- Razzak, M.T.; Darwis, D. Irradiation of polyvinyl alcohol and polyvinyl pyrrolidone blended hydrogel for wound dressing. Radiat. Phys. Chem. 2001, 62, 107–113. [Google Scholar] [CrossRef]
- Jiang, S.; Liu, S.; Feng, W.H. PVA hydrogel properties for biomedical application. J. Mech. Behav. Biomed. Mater. 2011, 4, 1228–1233. [Google Scholar] [CrossRef] [PubMed]
- Kamoun, E.A.; Chen, X.; Eldin, M.S.M.; Kenawy, E.R.S. Crosslinked poly (vinyl alcohol) hydrogels for wound dressing applications: A review of remarkably blended polymers. Arab. J. Chem 2015, 8, 1–14. [Google Scholar] [CrossRef]
- Sonker, A.K.; Rathore, K.; Teotia, A.K.; Kumar, A.; Verma, V. Rapid synthesis of high strength cellulose-poly(vinyl alcohol) (PVA) biocompatible composite films via microwave crosslinking. J. Appl. Polym. Sci. 2019, 136. [Google Scholar] [CrossRef]
- Ahmadian, Y.; Bakravi, A.; Hashemi, H.; Namazi, H. Synthesis of polyvinyl alcohol/CuO nanocomposite hydrogel and its application as drug delivery agent. Polym. Bull. 2019, 76, 1967–1983. [Google Scholar] [CrossRef]
- Tanan, W.; Panichpakdee, J.; Saengsuwan, S. Novel biodegradable hydrogel based on natural polymers: Synthesis, characterization, swelling/reswelling and biodegradability. Eur. Polym. J. 2019, 112, 678–687. [Google Scholar] [CrossRef]
- Gao, T.L.; Jiang, M.H.; Liu, X.Q.; You, G.J.; Wang, W.Y.; Sun, Z.H.; Ma, A.G.; Chen, J. Patterned Polyvinyl Alcohol Hydrogel Dressings with Stem Cells Seeded for Wound Healing. Polymers 2019, 11, 171. [Google Scholar] [CrossRef]
- Hago, E.E.; Li, X.S. Interpenetrating Polymer Network Hydrogels Based on Gelatin and PVA by Biocompatible Approaches: Synthesis and Characterization. Adv. Mater. Sci. Eng. 2013. [Google Scholar] [CrossRef]
- Mahnama, H.; Dadbin, S.; Frounchi, M.; Rajabi, S. Preparation of biodegradable gelatin/PVA porous scaffolds for skin regeneration. Artif. Cells Nanomed. Biotechnol. 2017, 45, 928–935. [Google Scholar] [CrossRef] [PubMed]
- Chen, L.; Cheng, H.H.; Xiong, J.; Zhu, Y.T.; Zhang, H.P.; Xiong, X.; Liu, Y.M.; Yu, J.; Guo, Z.X. Improved Mechanical Properties of Poly (butylene succinate) Membrane by Co-electrospinning with Gelatin. Chin. J. Polym. Sci. 2018, 36, 1063–1069. [Google Scholar] [CrossRef]
- Xing, Q.; Yates, K.; Vogt, C.; Qian, Z.C.; Frost, M.C.; Zhao, F. Increasing Mechanical Strength of Gelatin Hydrogels by Divalent Metal Ion Removal. Sci. Rep. 2014, 4, 4706. [Google Scholar] [CrossRef] [PubMed]
- Rathna, G.V.N.; Chatterji, P.R. Swelling kinetics and mechanistic aspects of thermosensitive interpenetrating polymer networks. J. Macromol. Sci. Pure Appl. Chem. 2001, 38, 43–56. [Google Scholar] [CrossRef]
- Zhu, Y.N.; Zhang, J.M.; Song, J.Y.; Yang, J.; Xu, T.; Pan, C.; Zhang, L. One-step synthesis of an antibacterial and pro-healing wound dressing that can treat wound infections. J. Mater. Chem. B 2017, 5, 8451–8458. [Google Scholar] [CrossRef] [PubMed]
- Cao, Z.N.; Luo, X.G.; Zhang, H.; Fu, Z.; Shen, Z.; Cai, N.; Xue, Y.A.; Yu, F.Q. A facile and green strategy for the preparation of porous chitosan-coated cellulose composite membranes for potential applications as wound dressing. Cellulose 2016, 23, 1349–1361. [Google Scholar] [CrossRef]
- Oliveira, R.N.; McGuinness, G.B.; Ramos, M.E.T.; Kajiyama, C.E.; Thire, R. Properties of PVA Hydrogel Wound-Care Dressings Containing UK Propolis. Macromol. Symp. 2016, 368, 122–127. [Google Scholar] [CrossRef]
- Wang, T.; Zhu, X.K.; Xue, X.T.; Wu, D.Y. Hydrogel sheets of chitosan, honey and gelatin as burn wound dressings. Carbohydr. Polym. 2012, 88, 75–83. [Google Scholar] [CrossRef]
- Varaprasad, K.; Mohan, Y.M.; Vimala, K.; Raju, K.M. Synthesis and Characterization of Hydrogel-Silver Nanoparticle-Curcumin Composites for Wound Dressing and Antibacterial Application. J. Appl. Polym. Sci. 2011, 121, 784–796. [Google Scholar] [CrossRef]
- Kokabi, M.; Sirousazar, M.; Hassan, Z.M. PVA-clay nanocomposite hydrogels for wound dressing. Eur. Polym. J. 2007, 43, 773–781. [Google Scholar] [CrossRef]
- Kamoun, E.A.; Kenawy, E.R.S.; Tamer, T.M.; El-Meligy, M.A.; Eldin, M.S.M. Poly (vinyl alcohol)-alginate physically crosslinked hydrogel membranes for wound dressing applications: Characterization and bio-evaluation. Arab. J. Chem. 2015, 8, 38–47. [Google Scholar] [CrossRef]
- Wen, X.; Cao, X.L.; Yin, Z.H.; Wang, T.; Zhao, C.S. Preparation and characterization of konjac glucomannan-poly (acrylic acid) IPN hydrogels for controlled release. Carbohydr. Polym. 2009, 78, 193–198. [Google Scholar] [CrossRef]
- Chen, X.L.; Chen, Q.H.; Yan, T.T.; Liu, J.K. Characterization of konjac glucomannan-gelatin IPN physical hydrogel scaffold. IOP Conf. Ser. Mater. Sci. Eng. 2017, 207, 012029. [Google Scholar] [CrossRef]
- Huang, Y.C.; Chu, H.W.; Huang, C.C.; Wu, W.C.; Tsai, J.S. Alkali-treated konjac glucomannan film as a novel wound dressing. Carbohyd. Polym. 2015, 117, 778–787. [Google Scholar] [CrossRef]
- Hwang, M.R.; Kim, J.O.; Lee, J.H.; Kim, Y.I.; Kim, J.H.; Chang, S.W.; Jin, S.G.; Kim, J.A.; Lyoo, W.S.; Han, S.S.; et al. Gentamicin-loaded wound dressing with polyvinyl alcohol/dextran hydrogel: Gel characterization and In Vivo healing evaluation. AAPS Pharmscitech 2010, 11, 1092–1103. [Google Scholar] [CrossRef]

| Color Values | Implications |
|---|---|
| 1.6 < ΔE < 3.2 | Cannot distinguish its color difference |
| 3.2 < ΔE < 6.5 | A few people can tell the difference in colors |
| 6.5 < ΔE < 13 | The color difference is very obvious |
| 13 < ΔE < 25 | Most belong to different colors |
| ΔE > 25 | Different colors |
| FG Content (%) | Distilled Water | Normal Saline | ||
|---|---|---|---|---|
| n | R2 | n | R2 | |
| 0.00 | 0.6028 | 0.9977 | 0.6130 | 0.9986 |
| 0.75 | 0.5832 | 0.9991 | 0.5795 | 0.9997 |
| 1.50 | 0.5631 | 0.9996 | 0.5444 | 0.9998 |
| 2.25 | 0.5454 | 0.9990 | 0.5276 | 0.9999 |
| 3.00 | 0.5255 | 0.9999 | 0.5141 | 0.9999 |
© 2020 by the authors. Licensee MDPI, Basel, Switzerland. This article is an open access article distributed under the terms and conditions of the Creative Commons Attribution (CC BY) license (http://creativecommons.org/licenses/by/4.0/).
Share and Cite
Ren, T.; Gan, J.; Zhou, L.; Chen, H. Physically Crosslinked Hydrogels Based on Poly (Vinyl Alcohol) and Fish Gelatin for Wound Dressing Application: Fabrication and Characterization. Polymers 2020, 12, 1729. https://doi.org/10.3390/polym12081729
Ren T, Gan J, Zhou L, Chen H. Physically Crosslinked Hydrogels Based on Poly (Vinyl Alcohol) and Fish Gelatin for Wound Dressing Application: Fabrication and Characterization. Polymers. 2020; 12(8):1729. https://doi.org/10.3390/polym12081729
Chicago/Turabian StyleRen, Teng, Jing Gan, Liping Zhou, and Hao Chen. 2020. "Physically Crosslinked Hydrogels Based on Poly (Vinyl Alcohol) and Fish Gelatin for Wound Dressing Application: Fabrication and Characterization" Polymers 12, no. 8: 1729. https://doi.org/10.3390/polym12081729
APA StyleRen, T., Gan, J., Zhou, L., & Chen, H. (2020). Physically Crosslinked Hydrogels Based on Poly (Vinyl Alcohol) and Fish Gelatin for Wound Dressing Application: Fabrication and Characterization. Polymers, 12(8), 1729. https://doi.org/10.3390/polym12081729

